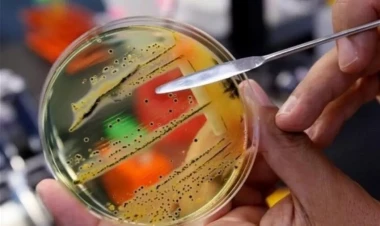
Bu ölkədə epidemiya yayıldı, ölənlər var

Dünya
İran: Dost ölkələrlə buna hazırıq
İran Rusiya da daxil olmaqla, dost ölkələrlə qaz sənayesində istehsal olunan texnologiya...
"Bayden ABŞ demokratiyası üçün təhlükədir"
Hazırkı prezident Co Bayden siyasi rəqiblərini məhkəmədə mühakimə etməklə ABŞ demokratiyasına...
Zelenskinin qatıldığı tədbiri BOYKOT ETDİ
Kiyevin meri Vitali Kliçko Ukrayna rəhbəri Volodimir Zelenskinin iştirakı ilə keçirilən...
Türkiyədə bələdiyyə sədrlərinin adları bu tarixdə açıqlanacaq
Türkiyədə 27 dekabr tarixində böyük şəhərlərin bələdiyyə sədrliyinə namizəd olanların...
Dəhşətli hadisə: Ananın diqqətsizliyi az qala faciəyə səbəb...
İzmirdə ananın ehtiyatsızlığı onun körpəsinin xəsarət alması ilə nəticələnib.
“İsrail HƏMAS-a maksimum hərbi təzyiq göstərməyə davam...
İsrail Qəzza zolağında saxlanılan girovların geri qaytarılmasını təmin etmək və...
Dövlət işçilərinə “Apple” qadağası
Çinin səkkiz vilayətində dövlət şirkətləri və hökumət tərəfindən dəstəklənən təşkilatlar...
NASA xəbərdarlıq etdi: Sabahdan etibarən yer kürəsində…
NASA son 6 ildəki ən güclü Günəş partlayışının yaşandığını açıqlayıb.
MOSSAD HƏMAS-la bağlı xəbərdarlıq edibmiş…
İsrail kəşfiyyatı HƏMAS-ın hücumundan əvvəl bir sıra investisiya şirkətləri vasitəsilə...
Zaxarova: Bu, onların özünə daha çox zərər verəcək
Avropa İttifaqının yeni anti-Rusiya sanksiyalar paketi, bütün əvvəlkilər kimi, Aİ-nin...
Azərbaycanda işədüzəltmə adıyla aldadıldılar
Hindistanda vətəndaşları Azərbaycanda işədüzəltmə adıyla aldadan şirkətlərin rəhbəri...
ABŞ generalı İsrailə gəldi
ABŞ Mərkəzi Komandanlığının rəhbəri general Maykl Kurilla İsrailə səfər edib.
Mərcan adaları yox olmaq ərəfəsindədir
Avstraliyanın dəniz sərhədlərində yerləşən 10-dan çox mərcan adası yox olma təhlükəsi...
Mərcan adaları yox olmaq ərəfəsindədir
Avstraliyanın dəniz sərhədlərində yerləşən 10-dan çox mərcan adası yox olma təhlükəsi...
Bu ölkədə epidemiya yayıldı, ölənlər var
Kanadanın səkkiz regionunda epidemiya nəticəsində 6 nəfər ölüb, daha 153 nəfər salmonellyoz...
Britaniyanın fəxri konsulu qaçırıldı
Böyük Britaniyanın Quayakildəki fəxri konsulu Kolin Armstronq qaçırılıb.